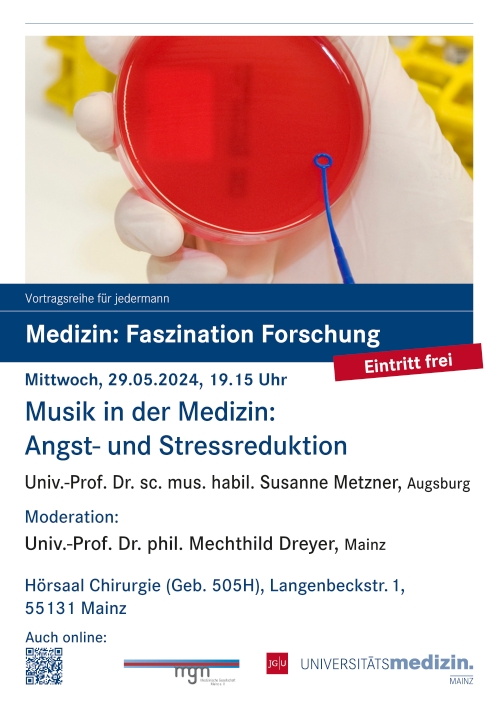

Die Plakate zu unseren Veranstaltungen im Jahr 2024
© Alle Rechte an den Plakaten verbleiben bei der Medizinischen Gesellschaft Mainz.




















 |
|||
|
Die Plakate zu unseren Veranstaltungen im Jahr 2024 |
|||
|
|
© Alle Rechte an den Plakaten verbleiben bei der Medizinischen Gesellschaft Mainz. |
||
 |
 |
||
 |
 |
||
 |
 |
||
 |
 |
||
 |
 |
||
|
 |
||
 |
 |
||
 |
 |
||
 |
 |
||
 |
 |
||
|
E-Mail an die mgm e. V. - © 2008 - 2026 - Impressum - Links - Medizinische Gesellschaft Mainz e. V. - E-Mail an den Webmaster |